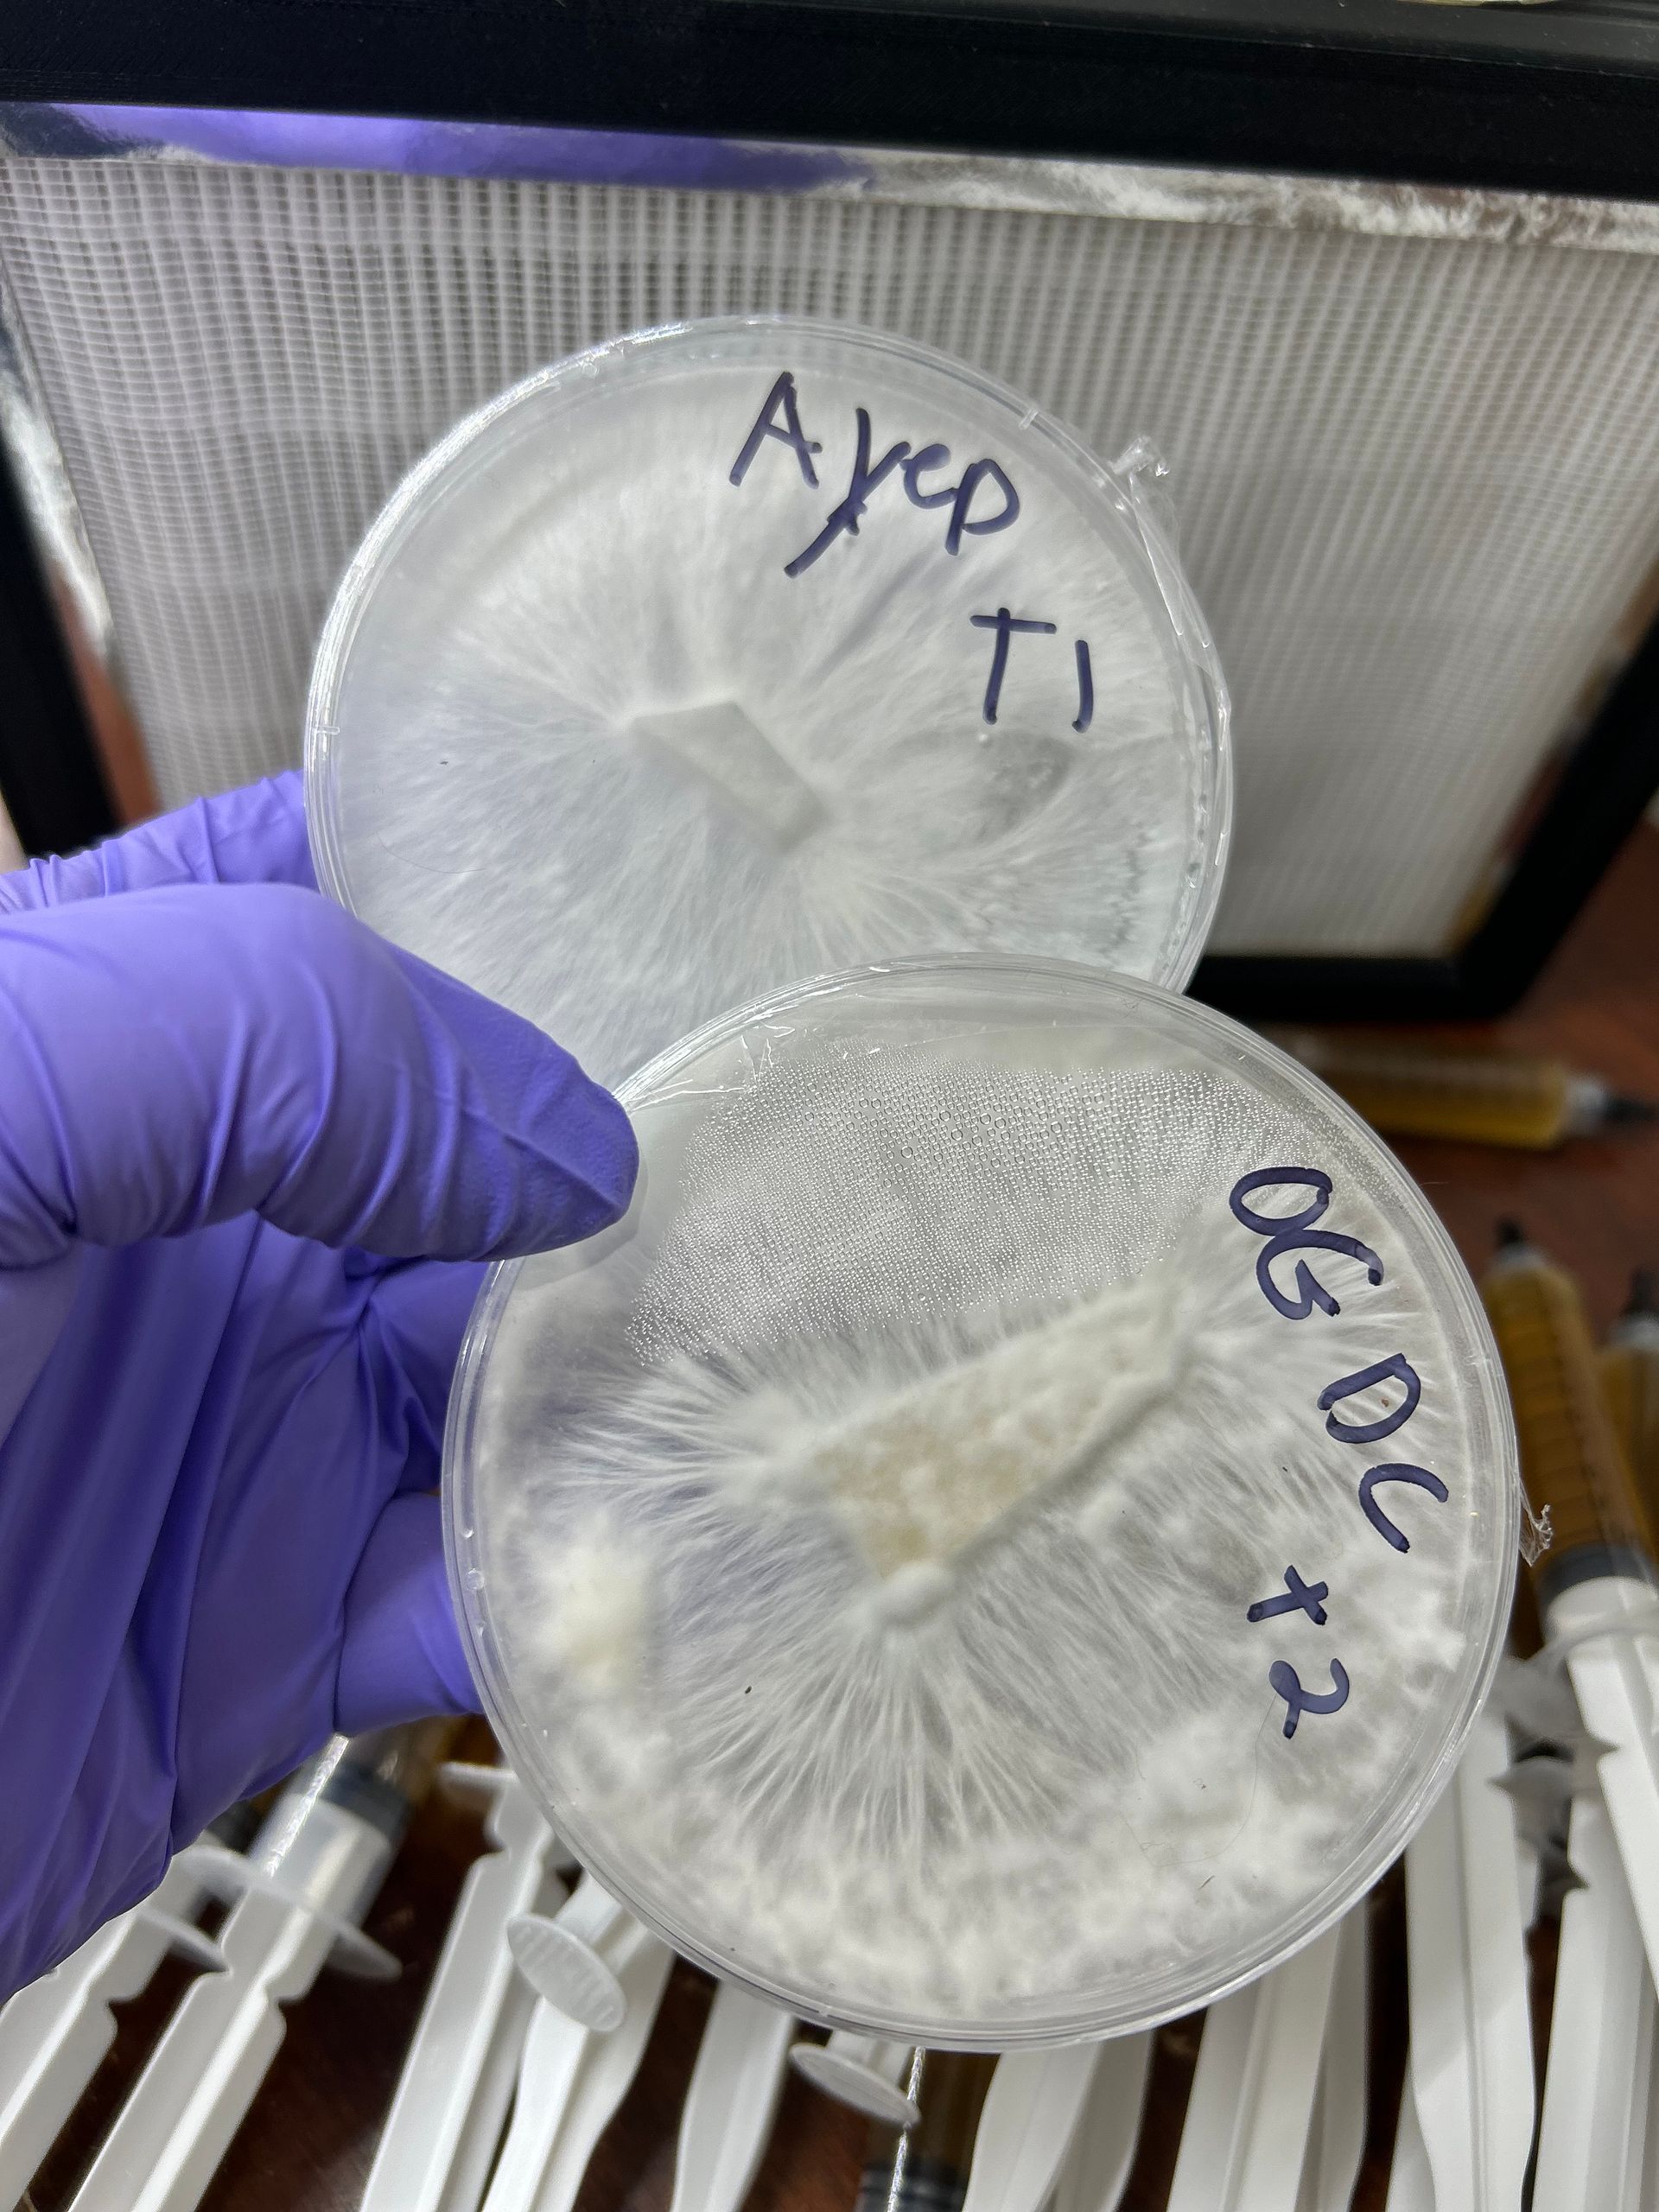
Colonized Agar Dishes
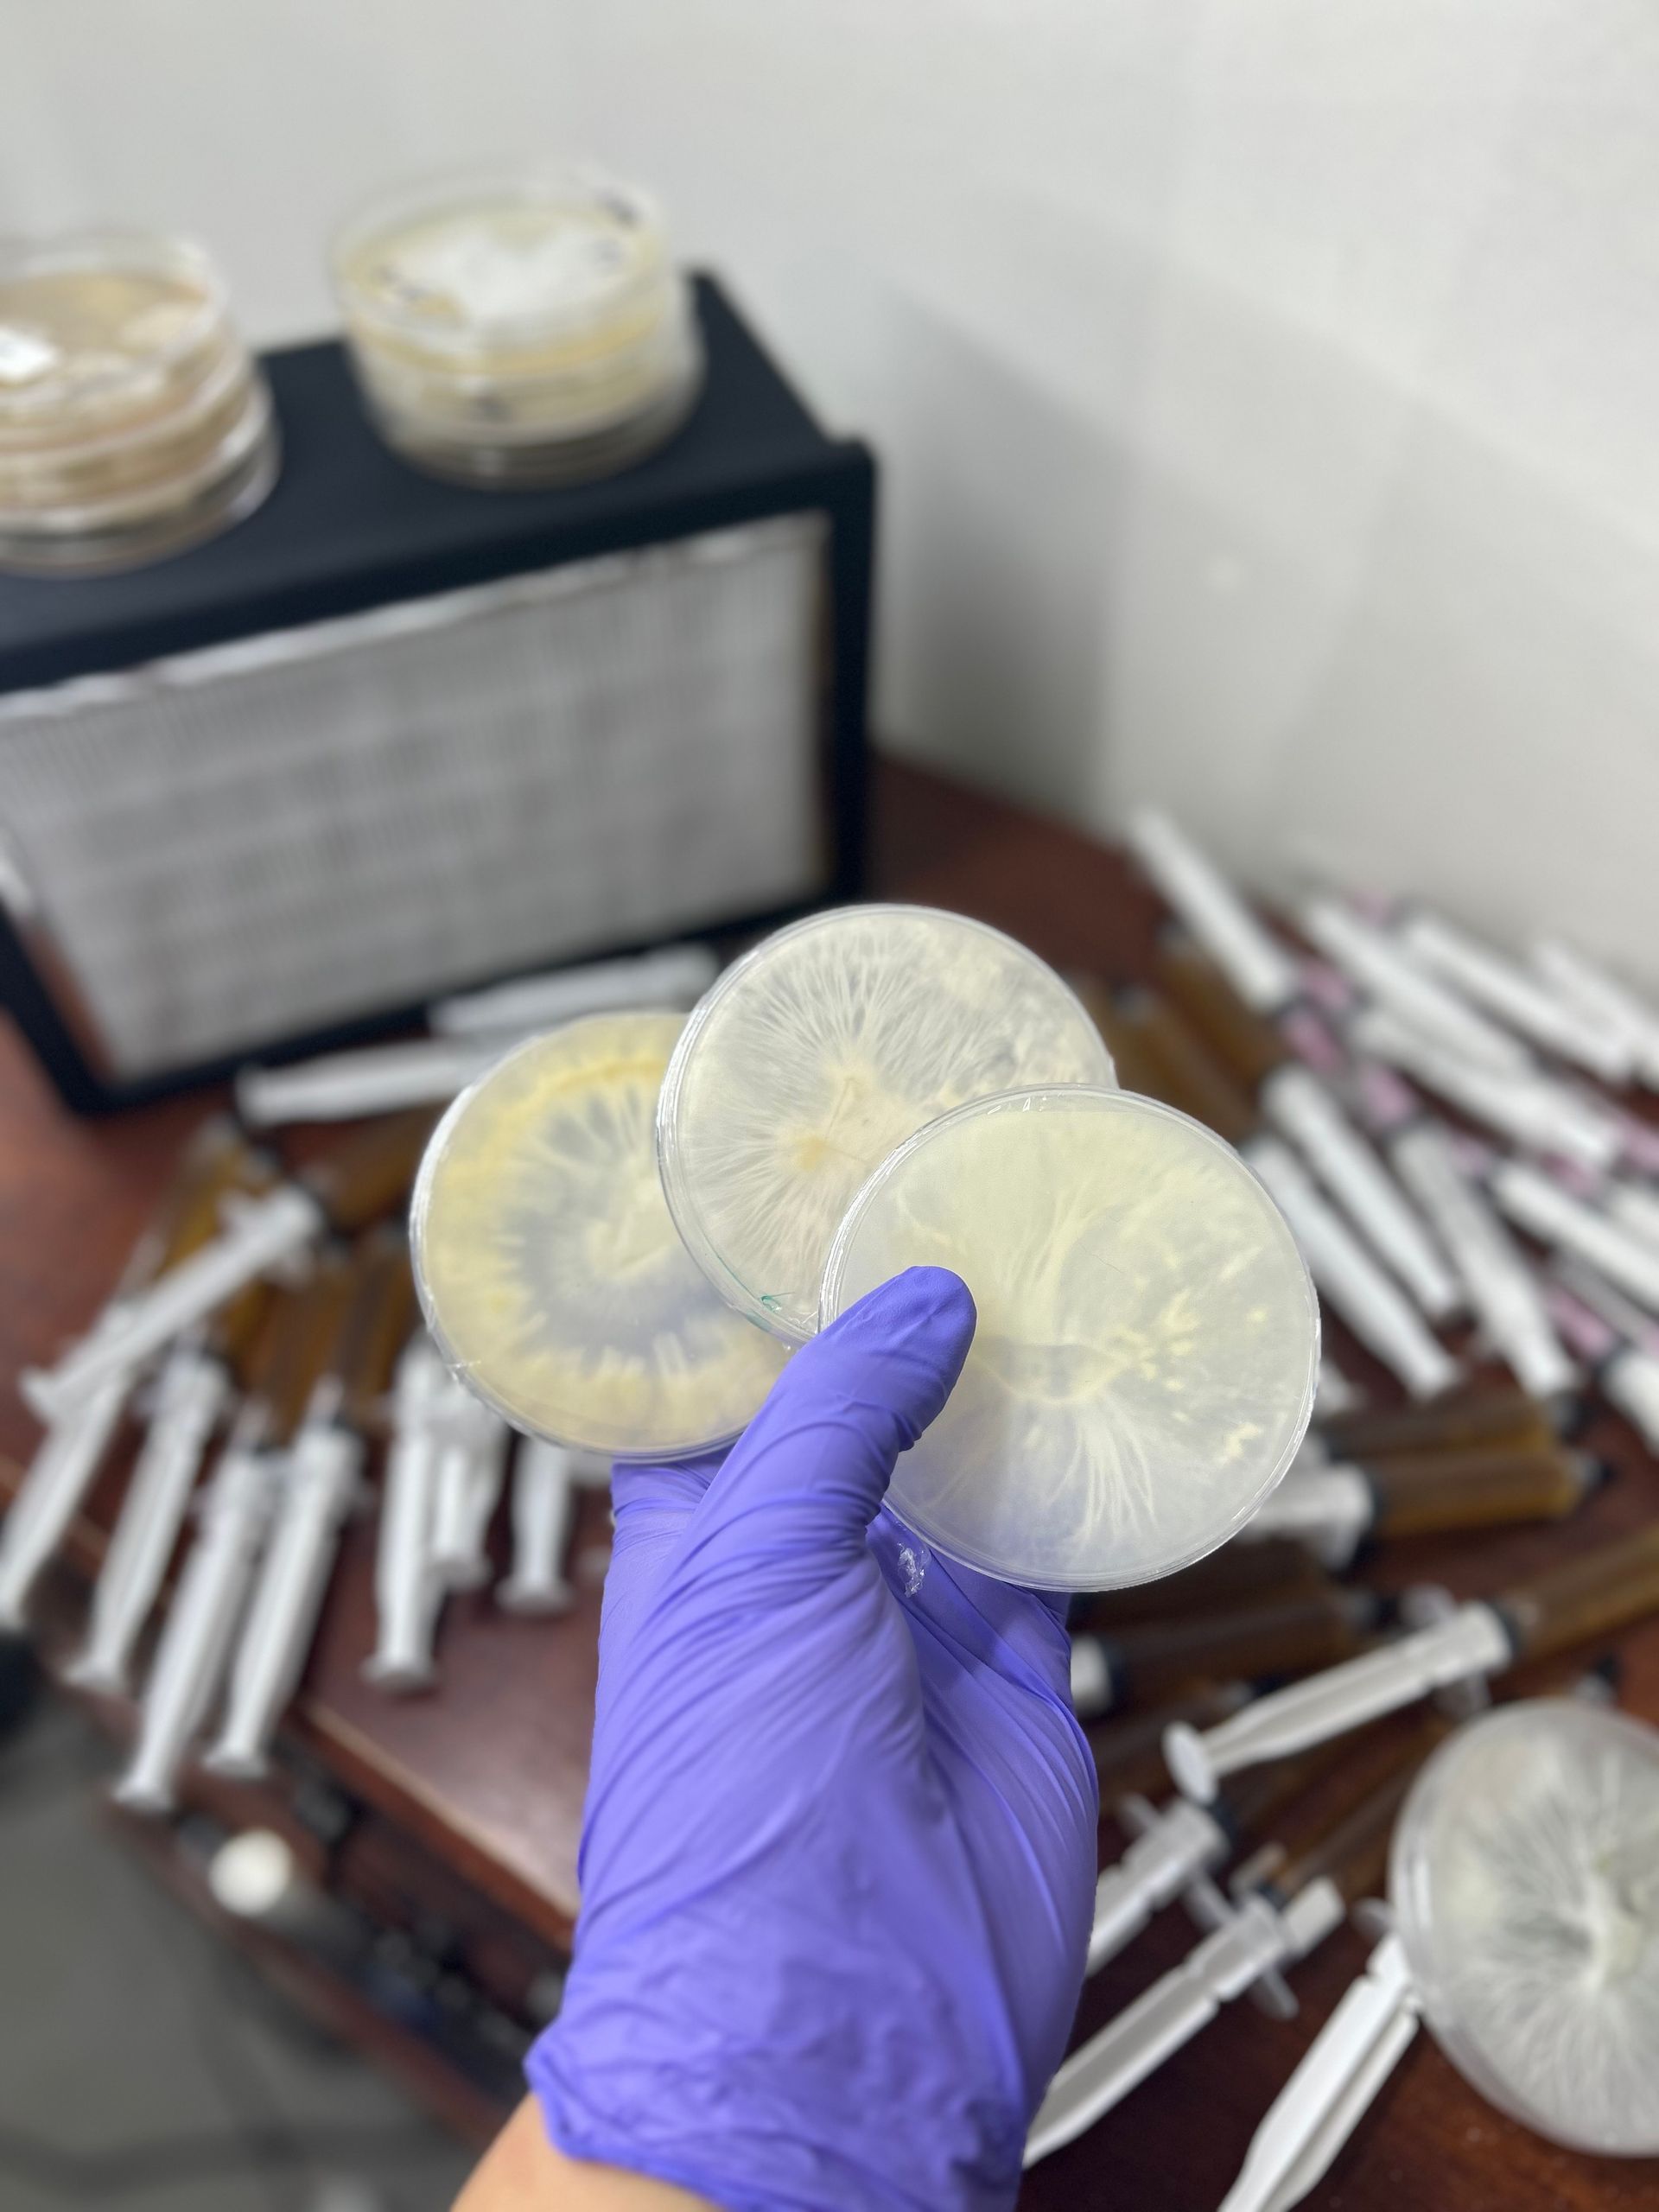
Colonized Agar Dishes

QUALITY AND QUANTITY YOU CAN TRUST
Everything you need to level up your mycology experience. From consultation to bulk sub and grain and more give us a call I'm sure there's something we can do to help your company thrive!
Shop best sellers
-
Colonized Agar Dishes
Xe37fDAW$15.44* Includes taxesButton -
10ML Liquid Culture Syringe
m51zWNaL$15.44* Includes taxesButton